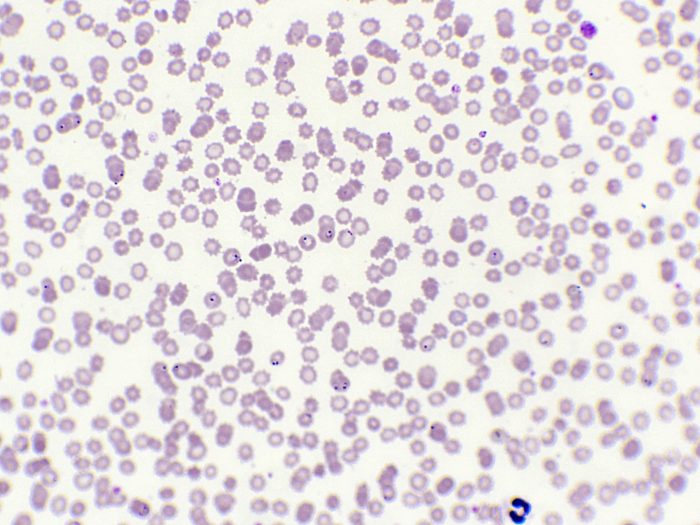
760F Plasmodium dans le sang x400

Bégénat, fournisseur expert en accompagnement pédagogique pour l’enseignement des sciences
Découvrez nos 5 grandes familles de produits
Expédition sous 48 h en France métropolitaine
Produits pédagogiques éprouvés en situation réelle
+ 30 ans d’expérience au service de l’enseignement
Service client réactif & spécialisé éducation
Nos produits phares
Des produits adaptées au niveau d’enseignement
Collège
Matériel pour le collègeLycée
Équipements lycée SVTUniversité
Solutions universitairesRessources pédagogiques
Enrichissez vos cours de SVT avec des contenus prêts à l’emploi, conçus pour faciliter votre quotidien d’enseignant. Nous mettons à votre disposition une bibliothèque exclusive de fiches pédagogiques gratuites, élaborées en collaboration avec des professeurs de sciences expérimentés.
Accéder aux Ressources

Ce qui fait notre différence depuis 30 ans
Découvrir l’entrepriseUne expertise de terrain depuis plus de 30 ans
Depuis 1990, nous fournissons du matériel pédagogique fiable et adapté aux classes, conçu avec et pour les enseignants.
Entreprise française, 1 600 références disponibles
Entreprise familiale, nous proposons un large catalogue SVT pour collèges, lycées et universités, en évolution constante.
Des solutions conformes aux programmes
Nos équipements couvrent tous les niveaux, avec un seul objectif : éveiller la curiosité scientifique.
Les dernières nouvelles
Restez informé des nouveautés produits, innovations pédagogiques et évolutions du catalogue. Chaque mois, notre équipe vous partage les infos clés pour enrichir vos cours et anticiper vos besoins en SVT.
Voir toutes les actualitésL’importance de l’apprentissage des sciences chez l’enfant
CMEX-Explorer les nouvelles caméras destinées à l’enseignement
Bégénat est une entreprise française spécialisée dans la fabrication de préparations microscopiques, de kits de travaux pratiques et la distribution d’une large gamme de matériel pédagogique destiné à l’enseignement des sciences de la vie et de la Terre (SVT). Basée en Normandie, elle propose plus de 1 600 références et sert plus de 1 000 clients depuis plus de 30 ans.
Notre siège est situé au 8, impasse de la Mesnillière, 14790 Verson, France.
Téléphone : 02 31 26 62 83
Email : begenat@wanadoo.fr
Nous proposons des paiements sécurisés (via CB, virement bancaire, etc.).
Les établissements publics règlent par mandat administratif, La facture est déposée sur le site Chorus pro après l’expédition de la commande.
Les commandes sont expédiées dans un délai de 48/72 heures pour la France métropolitaine selon la disponibilité des articles.
Nous couvrons un large catalogue :
Biologie végétale, animale, bactériologie, génétique, etc.
Géologie : lames mines, roches, minéraux, fossiles, météorites…
Consommables de laboratoire, microscopes, modèles anatomiques, matériel d’éducation à la santé…
Oui, un nouveau catalogue est disponible pour chaque rentrée de Septembre, à consulter directement sur le site.
Oui, consultez la section Promotions du mois pour découvrir nos offres en cours.
Principalement des établissements scolaires publics et privés, collèges, lycées, universités et centres de formation, auprès desquels nous avons déjà servi plus de 1 000 équipes enseignantes.
Mais aussi des particuliers, des musées, des associations éducatives,,,